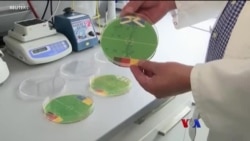

E-Coli ဘက်တီးရီးယားပိုးနဲ့ UEFA ရလာဒ်ခန့်မှန်း "ထူးခြားဆန်းပြားသတင်းများ"
ဂျာမဏီတက္ကသိုလ်တခုမှာ E-Coli အီကိုလိုင် ဘက်တီးရီးယားပိုးတွေကို ကြည့်ပြီး ယူရို ၂၀၂၄ ဘောလုံးပြိုင်ပွဲရလာဒ် ခန့်မှန်းချက်ထုတ်၊ အမေရိကားက ပုရစ်တွေ မှိုရောဂါ ကူးပြီး လိင်စိတ်ကြွတဲ့ ဇွန်ဘီဖုတ်ကောင်လေးတွေ ဖြစ်ကုန်၊ ဒီလို ထူးခြားဆန်းပြားသတင်းများကို ကိုငြိမ်းချမ်းနဲ့ မခင်ဖြူထွေးတို့ တင်ဆက်ထားပါတယ်။
ဗွီဒီယို ကြည့်ရှုရန်
-
![ဆောက်လုပ်ရေးမှာ လူတွေနဲ့ အလုပ်လုပ်တဲ့ စက်ရုပ် "ထူးခြားဆန်းပြားသတင်းများ"]() ၂၃ ဖေဖော်ဝါရီ၊ ၂၀၂၅
၂၃ ဖေဖော်ဝါရီ၊ ၂၀၂၅ဆောက်လုပ်ရေးမှာ လူတွေနဲ့ အလုပ်လုပ်တဲ့ စက်ရုပ် "ထူးခြားဆန်းပြားသတင်းများ"
-
![လူ့ကိုယ်ထဲ ဝင်ပြီး ဆေးပို့ဆောင်တဲ့ စက်ရုပ်နည်းပညာ "ထူးခြားဆန်းပြားသတင်းများ"]() ၁၆ ဖေဖော်ဝါရီ၊ ၂၀၂၅
၁၆ ဖေဖော်ဝါရီ၊ ၂၀၂၅လူ့ကိုယ်ထဲ ဝင်ပြီး ဆေးပို့ဆောင်တဲ့ စက်ရုပ်နည်းပညာ "ထူးခြားဆန်းပြားသတင်းများ"
-
![မျိုးဗီဇပြုပြင်မွေးထုတ်ထားတဲ့ ပထမဆုံးမြင်း "ထူးခြားဆန်းပြားသတင်းများ"]() ၀၉ ဖေဖော်ဝါရီ၊ ၂၀၂၅
၀၉ ဖေဖော်ဝါရီ၊ ၂၀၂၅မျိုးဗီဇပြုပြင်မွေးထုတ်ထားတဲ့ ပထမဆုံးမြင်း "ထူးခြားဆန်းပြားသတင်းများ"
-
![ရေအောက်ခန်းထဲ ၄ လ ကြာနေခဲ့သူ ကမ္ဘာ့စံချိန်ချိုး "ထူးခြားဆန်းပြားသတင်းများ"]() ၀၂ ဖေဖော်ဝါရီ၊ ၂၀၂၅
၀၂ ဖေဖော်ဝါရီ၊ ၂၀၂၅ရေအောက်ခန်းထဲ ၄ လ ကြာနေခဲ့သူ ကမ္ဘာ့စံချိန်ချိုး "ထူးခြားဆန်းပြားသတင်းများ"

Forum